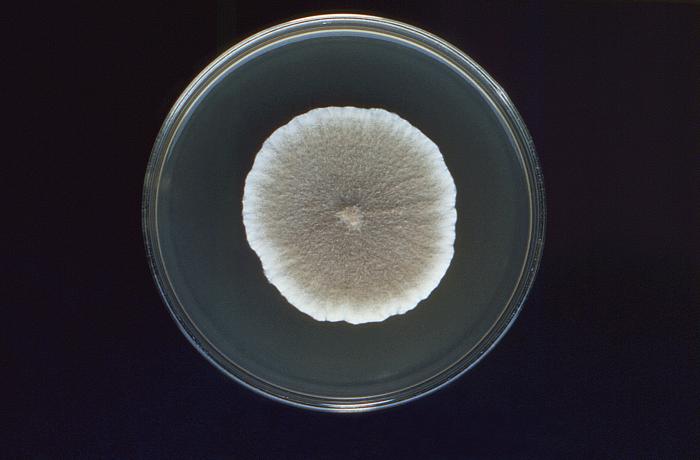

Scedosporium apiospermum es un hongo filamentoso hialino y perteneciente al filo Ascomycota.
Macroscopicamente crece rápidamente a 25 °C en agar Sabouraud pudiendo tolerar hasta 42 °C. Las colonias son de aspecto flocoso, inicialmente de colores blancos y después grisáceos pudiendo adquirir un color marrón, su reverso es pálido con zonas de color marrón o negro.
La apariencia microscópica depende de la especie y de la fase sexual.
S. apiospermum (forma anamorfa) presenta hifas hialinas, cilíndricas y septadas con células conidiogénicas emergiendo. Los conidios son ovales, únicos, truncos en su base, de color marrón y adherentes. Pseudallescheria boydii (forma teleomorfa) se caracteriza por la presencia del cleistotecio marrón en donde se producen los ascos globosos que contienen 8 ascosporas. Las ascosporas son unicelulares, ovoides o elipsoidales, lisas y de color amarillo pálido a cobre.
Viabilidad, propagación y transmisión
Reservorio
Suelo, materia orgánica en descomposición, fango, aguas residuales, agua salada y salobre.
Hospedadores
Humanos y, raramente, se ha documentado el aislamiento del hongo en anfibios (1).
Dosis Infectiva Mínima (DIM)
Se desconoce en la actualidad.
Supervivencia ambiental
Son hongos saprófitos, se encuentran en el suelo, en distintos sustratos ricos en materia orgánica (estiércol), en las aguas residuales y en los mares contaminados. También pueden encontrarse contaminando los sistemas de climatización-ventilación de los edificios.
S. apiospermum (Pseudallescheria boydii) se ha encontrado en agua salobre y salada, aguas residuales, suelo, zonas pantanosas, zonas costeras y en materia orgánica rica en compuestos nitrogenados como guano, estiércol y heces de murciélago.
Formas de resistencia
No presentan formas de resistencia.
Mecanismo de propagación y transmisión
La transmisión se produce principalmente por inoculación de las esporas del hongo en el tejido subcutáneo, mediante pinchazos o arañazos con objetos contaminados como espinas, paja, astillas, herramientas, clavos oxidados, etc.
Otra forma posible de transmisión es la inhalación de las esporas del hongo dispersas en el ambiente y, también, por la inmersión accidental prolongada en aguas contaminadas.
La mayor transmisión suele darse en actividades en contacto con suelo, tierra, estiércol, fango y aguas residuales (2).
También están relacionados con casos de enfermedad nosocomial, principalmente por traumatismos penetrantes, cirugía, catéteres intravasculares, punciones lumbares o inhalación de esporas ambientales.
No se transmite de persona a persona, ni de los animales al hombre (1).
Vías de entrada
Parenteral. Respiratoria.
Distribución geográfica
Mundial.
Efectos sobre la salud
Grupo de riesgo
2
(Ver Anexo II RD 664/1997 )Infección
La infección da lugar a distintas manifestaciones clínicas según la puerta de entrada del hongo y el estado del paciente afectado. Las más habituales se pueden agrupar en micetoma; infección oportunista; infección no oportunista; y síndrome de asfixia por inmersión.
El micetoma (eumicetoma) es la infección más frecuente causada por estos hongos; se trata de una infección crónica, profunda, de progresión lenta, sin dolor y destructiva de la piel, el tejido subcutáneo, el músculo y el hueso. Normalmente afecta a los pies, pero puede afectar a cualquier parte del cuerpo, principalmente a las extremidades, la región glútea, la espalda, el tronco, la cabeza, el cuello, la cara, e incluso la conjuntiva. La lesión inicial es un nódulo eritematoso, indoloro, que crece y se fistuliza drenando material serosanguinolento (pus) y granos blancos o blanco-amarillentos (colonias del hongo). Con el tiempo y sin tratamiento la lesión se extiende hacia las zonas profundas como el músculo y el hueso subyacente, con la consecuente deformidad y pérdida de función del tejido afectado.
Aunque los micetomas se localizan en su mayor parte en las extremidades inferiores y pueden permanecer ahí durante años o décadas, la patología es más grave cuando se encuentra en sitios como el abdomen, donde puede causar peritonitis; el tórax, donde puede invadir los pulmones o mediastino; el cráneo, donde perfora los huesos y puede causar lesión cerebral o incluso la muerte.
Otras manifestaciones clínicas que pueden darse en individuos inmunocompetentes y en inmunodeprimidos son: afectación de las vías respiratorias (principalmente en pacientes con bronquiectasias), bola fúngica, reacción alérgica, neumonía, sinusitis, artritis séptica, osteomielitis, infección cutánea y subcutánea (no micetoma), meningitis, abscesos en el sistema nervioso central, queratitis, endoftalmitis, endocarditis y enfermedad diseminada especialmente en inmunocomprometidos (pacientes hematológicos, receptores de trasplantes o tratados con corticoides).
El síndrome de asfixia por inmersión es causado normalmente por S. apiospermum (P. boydii), afecta a pacientes inmunocompetentes tras haber sufrido un proceso de semiafixia por inmersión accidental prolongada en aguas contaminadas o por tsunamis. Se caracteriza por un síndrome clínico de infección sinopulmonar y afectación del sistema nervioso central. Las manifestaciones clínicas son muy diversas pero suelen incluir fiebre, cefalea, alteración de la conciencia, convulsiones y signos piramidales. La tasa de supervivencia no supera el 33 % (2).
Efectos alérgicos (Ver Anexo II RD 664/1997 ) / (Ver Allergen )
No se han descrito
Efectos tóxicos (Ver Anexo II RD 664/1997 )
No se han descrito
Efectos cancerígenos (Ver International Agency for Research On Cancer - IARC )
No se han descrito
Efectos en la maternidad
No se han descrito
Enfermedad
| CIE-10 | Nombre | Enfermedad de Declaración Obligatoria |
|---|---|---|
| B47 | Micetoma | No |
Actividades laborales con riesgo
Clasificación Nacional de Actividades Económicas (CNAE)
| CNAE 2009 | Descripción |
|---|---|
| A0111 | Cultivo de cereales, distintos de arroz, leguminosas y oleaginosas |
| A0113 | Cultivo de hortalizas, raíces y tubérculos |
| A0114 | Cultivo de caña de azúcar |
| A0116 | Cultivo de plantas para fibras textiles |
| A0130 | Propagación de plantas |
| A0150 | Producción agrícola combinada con la producción ganadera |
| A0161 | Actividades de apoyo a la agricultura |
| A0163 | Actividades de preparación posterior a la cosecha y tratamiento de semillas para reproducción |
| A0210 | Silvicultura y otras actividades forestales |
| A0220 | Explotación de la madera |
| A0230 | Recolección de productos silvestres, excepto madera |
| E3600 | Captación, depuración y distribución de agua |
| E3700 | Recogida y tratamiento de aguas residuales |
| E3811 | Recogida de residuos no peligrosos |
| F4211 | Construcción de carreteras y autopistas |
| F4212 | Construcción de vías férreas de superficie y subterráneas |
| F4213 | Construcción de puentes y túneles |
| F4221 | Construcción de redes para fluidos |
| F4291 | Obras hidráulicas |
| F4299 | Construcción de otros proyectos de ingeniería civil n.c.o.p. |
| F4312 | Preparación de terrenos |
| F4313 | Perforaciones y sondeos |
| N7210 | Investigación y desarrollo experimental en ciencias naturales y técnicas |
| N7500 | Actividades veterinarias |
| O8130 | Actividades de jardinería |
| P8424 | Orden público y seguridad |
| R8699 | Otras actividades sanitarias n.c.o.p. |
| S9122 | Actividades de sitios históricos y monumentos |
| S9141 | Actividades de los jardines botánicos y los parques zoológicos |
| T9630 | Pompas fúnebres y actividades relacionadas |
Clasificación Nacional de Ocupaciones (CNO)
| CNO 2011 | Descripción |
|---|---|
| 0020 | Tropa y marinería de las fuerzas armadas |
| 2130 | Veterinarios |
| 2210 | Profesores de universidades y otra enseñanza superior (excepto formación profesional) |
| 2421 | Biólogos, botánicos, zoólogos y afines |
| 2432 | Ingenieros en construcción y obra civil |
| 2454 | Ingenieros geógrafos y cartógrafos |
| 2462 | Ingenieros técnicos de obras públicas |
| 2483 | Ingenieros técnicos en topografía |
| 2821 | Sociólogos, geógrafos, antropólogos, arqueólogos y afines |
| 3122 | Técnicos en construcción |
| 3141 | Técnicos en ciencias biológicas (excepto en áreas sanitarias) |
| 3313 | Técnicos en anatomía patológica y citología |
| 3314 | Técnicos en laboratorio de diagnóstico clínico |
| 3327 | Ayudantes de veterinaria |
| 5892 | Empleados de pompas fúnebres y embalsamadores |
| 5931 | Bomberos (excepto forestales) |
| 5993 | Agentes forestales y medioambientales |
| 6110 | Trabajadores cualificados en actividades agrícolas (excepto en huertas, invernaderos, viveros y jardines) |
| 6120 | Trabajadores cualificados en huertas, invernaderos, viveros y jardines |
| 8331 | Operadores de maquinaria de movimientos de tierras y equipos similares |
| 9511 | Peones agrícolas (excepto en huertas, invernaderos, viveros y jardines) |
| 9512 | Peones agrícolas en huertas, invernaderos, viveros y jardines |
| 9530 | Peones agropecuarios |
| 9543 | Peones forestales y de la caza |
| 9601 | Peones de obras públicas |
| 9602 | Peones de la construcción de edificios |
| 9603 | Peones de la minería, canteras y otras industrias extractivas |
| 9811 | Peones del transporte de mercancías y descargadores |
Prevención y control
Desinfectantes
No se dispone de información específica para Scedosporium, pero la mayoría de los hongos son sensibles a hipoclorito sódico, yodóforos, alcoholes, glutaraldehído y peróxido de hidrógeno.
Inactivación física
No se dispone de información específica para Scedosporium, pero la mayoría de los hongos se inactivan con calor húmedo a 121 º C durante al menos 15 minutos.
Antimicrobianos
S. apiospermum (P. boydii) es sensible a las equinocandinas (principalmente a la caspofungina) y a los azoles (principalmente voriconazol) excepto a fluconazol y ketoconazol.
Vacunación
No disponible
Medidas preventivas generales
Disponer de ventilación adecuada en los lugares de trabajo, evitar la humedad relativa alta y condensaciones, además de implantar un programa periódico de limpieza y mantenimiento de locales, instalaciones y equipos, especialmente del sistema de climatización-ventilación del edificio.
Evitar procesos pulvígenos o que generen bioaerosoles; si no es posible, cerramiento o aislamiento de dichos procesos, o disponer de un sistema de extracción localizada.
Reducir el uso de herramientas cortantes o punzantes; en caso necesario, utilizarlas con las debidas precauciones y protecciones.
Higiene personal, mantener la piel limpia y seca, lavado de manos después de tocar materiales o elementos potencialmente contaminados. Utilización de ropa de trabajo y equipos de protección individual, sobre todo calzado y guantes, en la medida de lo posible, resistentes a la perforación.
Limpieza y desinfección de cortes, arañazos o heridas en la piel, evitar el contacto de las mismas con elementos contaminados. Cubrir las heridas con apósitos estériles e impermeables.
Precauciones en centros sanitarios
En hospitales y centros sanitarios, adoptar las Precauciones Estándar (8).
EPI
Protección de las manos: guantes de protección frente a microorganismos y de cierta resistencia mecánica en caso de contacto o manipulación de materiales potencialmente infecciosos.
Calzado de trabajo de resistencia mecánica a la perforación.
Protección respiratoria: mascarillas autofiltrantes preferiblemente FFP3 o máscaras con filtros P3 en tareas que puedan generar bioaerosoles o polvo.
Protección ocular o facial: gafa de protección de montura universal en caso de riesgo de contacto accidental mano/guante contaminado-ojo, o pantalla de protección facial (símbolo de marcado en montura: 3) en caso de riesgo de exposición a salpicaduras, o gafa de protección de montura integral con hermeticidad frente a partículas (símbolo de marcado en montura: 4), en caso de riesgo de exposición a polvo.
Seguridad en laboratorio
Nivel de contención: 2
Los principales riesgos son la inoculación accidental, el contacto del hongo con la piel, la inhalación de bioaerosoles y las salpicaduras.
Las muestras más peligrosas son muestras ambientales contaminadas (suelo, agua residual, fangos) y cultivos del hongo.
Se requieren las prácticas y las medidas de contención de un nivel 2 de bioseguridad, evitar el empleo de material cortante o punzante, utilizar cabina de seguridad biológica en aquellas operaciones que impliquen la generación de bioaerosoles, proyecciones o salpicaduras y utilizar guantes frente a microorganismos en el caso de contacto con muestras contaminadas, y bata o ropa de trabajo.
Bibliografía
- Cortez, K. J., Roilides, E., Quiroz-Telles, F., Meletiadis, J., Antachopoulos, C., Knudsen, T., Buchanan, W., Milanovich, J., Sutton, D. A., Fothergill, A., Rinaldi, M. G., Shea, Y. R., Zaoutis, T., Kottilil, S., & Walsh, T. J. (2008). Infections caused by Scedosporium spp. Clinical microbiology reviews, 21(1), 157-197. DOI: 10.1128/CMR.00039-07.
- Pemán, J., & Salavert, M. (2014). Enfermedad fúngica invasora por Scedosporium, Fusarium y Mucor. Revista iberoamericana de micología, 31(4), 242-248.
- San Juan, R., Berenguer, J., & Aguado, J. M. (2003). Hongos filamentosos emergentes: Scedosporium. Sociedad Española de Enfermedades Infecciosas y Microbiología Clínica (SEIMC).
- Tapia, C. (2012). Retrato microbiológico: Scedosporium/Pseudallescheria. Revista chilena de infectología, 29(3), 335-336.
- Centers for Disease Control and Prevention (CDC). (2020). Biosafety in microbiological and biomedical laboratories (6th ed.).
- Institut National de Recherche et de Sécurité (INRS). (2023). Scedosporium apiospermum. BAse d'OBservation des Agents Biologiques (BAOBAB).
- Instituto Nacional de Seguridad e Higiene en el Trabajo (INSHT). (2014). Guía técnica para la evaluación y prevención de los riesgos relacionados con la exposición a agentes biológicos (2ª ed.).
- Servicio Riojano de Salud. (2008). Precauciones de aislamiento en centros sanitarios.
- World Health Organization (WHO). Mycetoma, chromoblastomycosis and other deep mycoses.